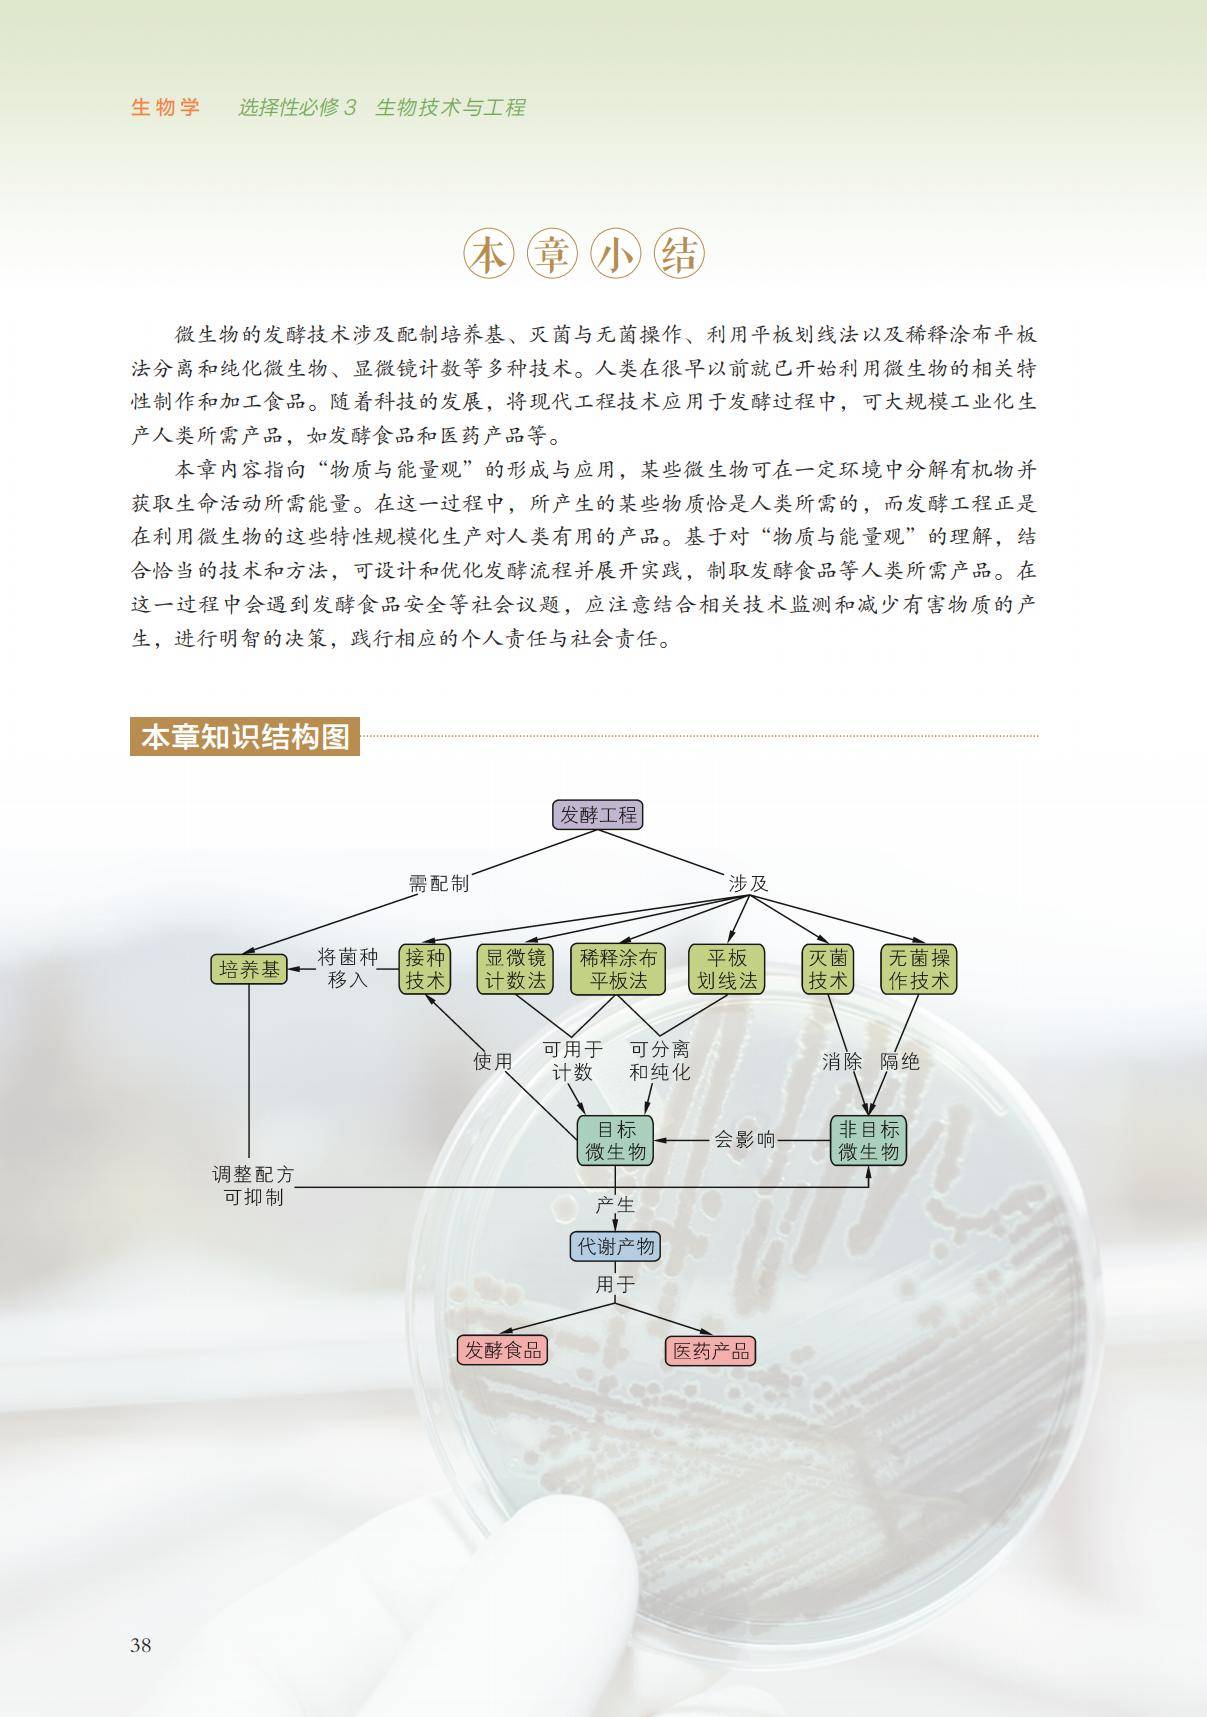

为了让大家做好课前预习和巩固复习,下面为大家准备了2026浙科版高中生物选择性必修三电子课本(高清版),大家可以在线浏览图片版,也可以下载高清PDF版以备不时之需,希望可以帮助到大家。
如需全套高中电子课本PDF版,请关注公众号“学习方法君”(ID:xuexiffj)回复:“电子课本”
浙科版高中生物选择性必修三电子课本在线阅读

《2026浙科版高中生物选择性必修三电子课本》就为您介绍到这里,资源来源于网络,仅为学习交流之目的进行分享,其版权均归原出版社及作者所有。
上一篇:利扬芯片:2月6日融券卖出345股,融资融券余额2.94亿元
下一篇:全球半导体市场景气度回升推动产业链活跃,泰康半导体量化选股股票发起式(A:020476;C:020477)跟踪指数强势涨超3%